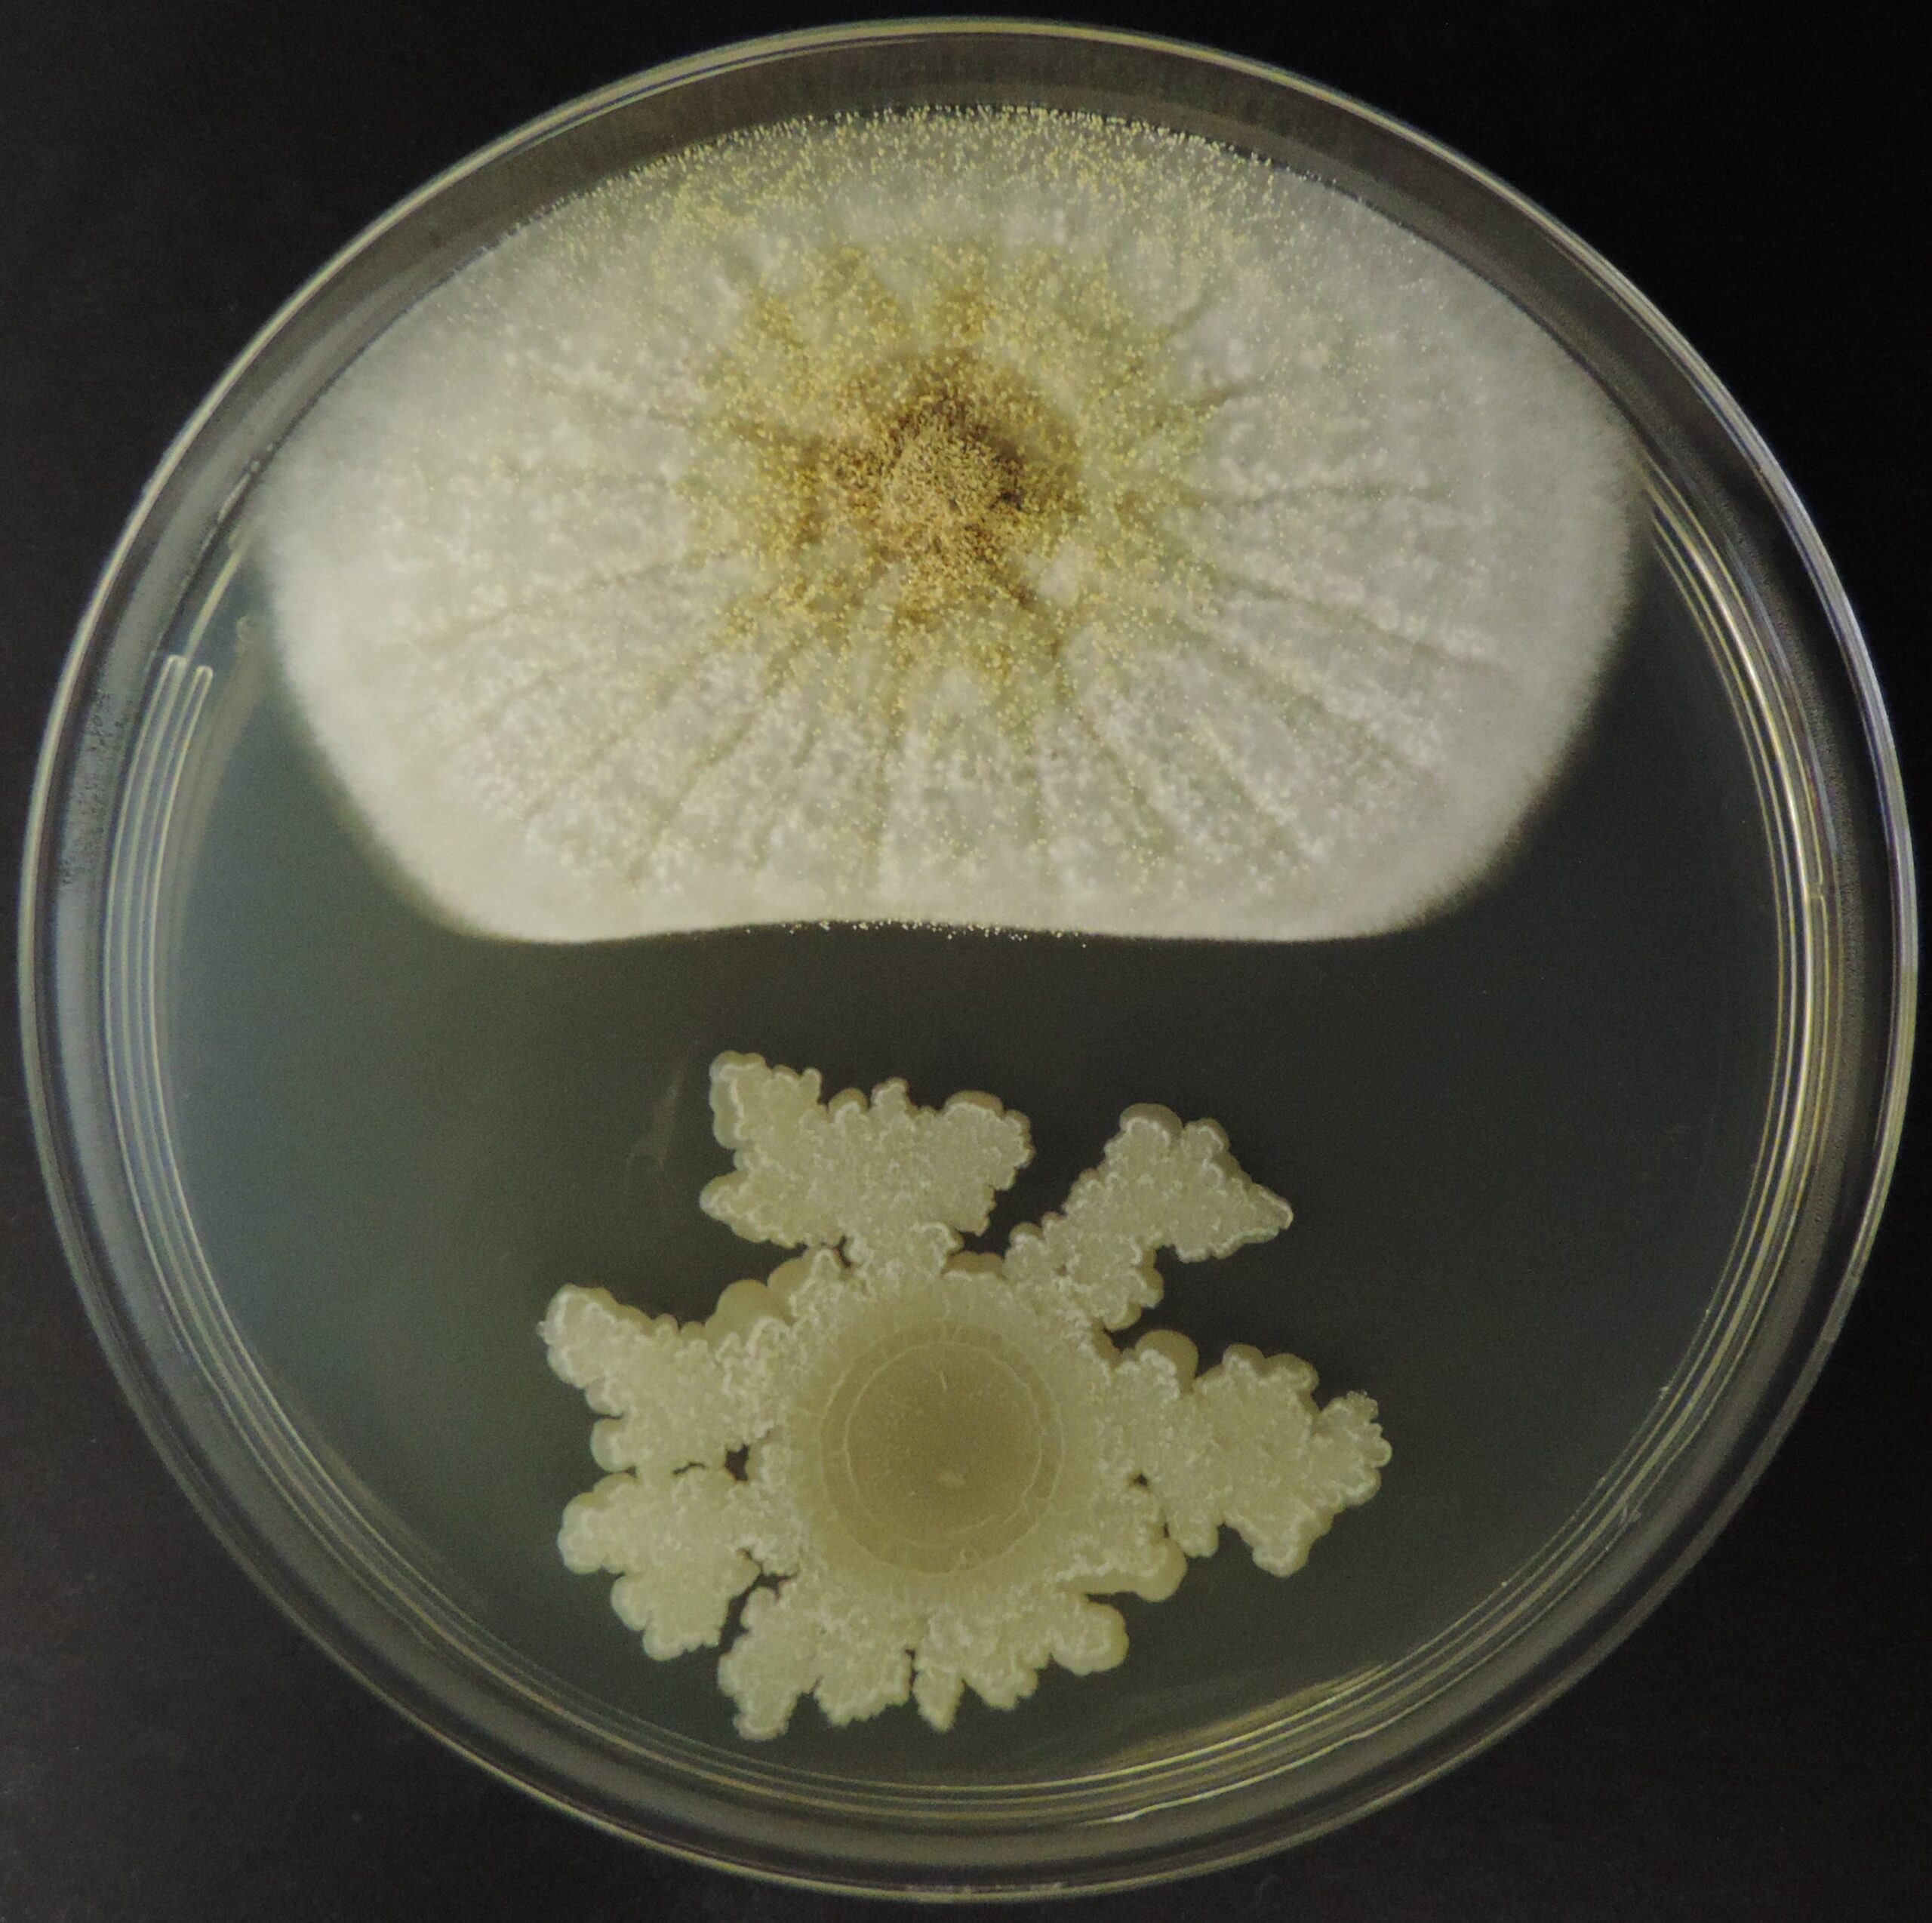

Anvisa recua e define que óleo de soja não apresenta alérgeno
Acompanhe a atualização deste assunto no post: Em nome das Boas Práticas Regulatórias, Anvisa revê decisão sobre alergênico em óleo de soja Recentemente, acompanhamos a

Acompanhe a atualização deste assunto no post: Em nome das Boas Práticas Regulatórias, Anvisa revê decisão sobre alergênico em óleo de soja Recentemente, acompanhamos a

Novamente nos deparamos com mais casos reais de presença de fragmento de pelo de roedor em produtos de tomate, acima do limite determinado pela legislação

Todos nós já lemos ao menos alguma notícia de recall de produtos à base de tomate, mais especificamente de catchup, devido à presença de fragmentos

Se você trabalha na indústria de embalagem para alimentos e se sua empresa está implementando a FSSC 22000 ou já é certificada, provavelmente você já

Se você é da indústria de embalagens para alimentos e ainda possui dúvidas em relação às legislações de Boas Práticas de Fabricação (BPF) que devem

Se você é estudante da área de alimentos e tem interesse em conhecer um pouco mais da rotina do responsável por segurança de alimentos, este

Você sabia que até o que a vaca come tem influência na nossa saúde? Uma pesquisa realizada em Santa Catarina investigou a presença de Aflatoxina

O Brasil está entre os 30 maiores produtores mundiais de pescado, ocupando a 19ª posição no último ranking divulgado, referente a produção do ano de

Recentemente publicamos sobre a presença de látex em toucas utilizadas na indústria. Uma leitora nos escreveu com a seguinte dúvida: “Mas como alergênico não seria

Natal é uma data festiva na qual muitas famílias e amigos se reúnem para celebrar. E claro, o que não pode faltar é a famosa

Durante o II Workshop Food Safety Brazil, que aconteceu em Londrina, dois participantes e leitores do nosso Blog, Andressa Nicolau e André Kutassy, levantaram uma

Comida japonesa é preferência de grande parte dos brasileiros e na última década houve um aumento significativo da quantidade de restaurantes especializados neste segmento. Você

Esse post foi elaborado a partir da transcrição do artigo da Angela Escosteguy, médica veterinária e atual Presidente do Instituto do Bem-Estar (IBEM – www.ibembrasil.org)
De 24 a 27 de outubro de 2016 aconteceu, em Gramado-RS, o XXV Congresso Brasileiro de Ciência e Tecnologia de Alimentos (CBCTA), e teve como

Como vimos em post recentemente aqui publicado, altos níveis de resíduos de pesticidas foram identificados em dezenas de amostras de alimentos, em estudo realizado pela

Como vimos em post recentemente publicado, altos níveis de resíduos de pesticidas foram identificados em dezenas de amostras de alimentos, em estudo realizado pela PROTESTE. Hoje

Cultivar horta em casa e comprar produtos orgânicos certificados é a sugestão da PROTESTE Associação de Consumidores, após constatar a presença de pesticidas, inclusive em

Já falamos bastante aqui sobre a RDC 26/15 e a necessidade de rotular alergênicos. Existe um deles, que não é tão comum ao nosso conhecimento

Compartilho com vocês a seguinte dúvida de um leitor: A minha dúvida é quando para um alérgeno há metodologia de validação apenas quantitativa, porém esta

No dia 21 de setembro, o Blog marcou presença em mais evento acadêmico. Desta vez foi no Rio de Janeiro, na UFRJ, durante a 83º

Recebemos a seguinte pergunta de um leitor: “Boa noite, gostaria de saber qual material plástico posso usar em contato direto com alimento que esteja em

Com a missão de estreitar as relações existente entre a academia e a cadeia produtiva de alimentos, nosso Blog tem um comitê de trabalho voltado

Com o aumento da rotatividade dos colaboradores, a realização de treinamentos de segurança de alimentos, às vezes, é quase que um retrabalho. Mas a única

No post que publiquei recentemente sobre embalagem celulósica (leia aqui), uma leitora perguntou: “a rotulagem de alergênicos leva em consideração a avaliação do produto após